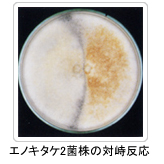

きのこの品種識別
対峙培養による簡易的な系統識別
菌糸を対峙して培養すると、品種が異なれば、明確に帯線を形成します。 帯線を形成しない場合は、同一品種か類似した品種と考えられ、さらに遺伝子解析を行ないます。

きのこの遺伝子解析による系統識別
バイオテクノロジー技術によりきのこの遺伝子を解析することで品種の異同を判別することができるようになってきました。現在、種苗法は野菜や花などの不正輸入を水際で排除できる規定になっていますが、品種の異同の判別が困難でした。最近は遺伝子の識別力が向上し、いくつかの作物はすでに遺伝子による品種識別が実現されています。きのこにおいても、様々な遺伝子の解析法が検討され、品種の判別技術が確立してきています。
当社では、平成23年度から農林水産省の補助事業を活用してSSR(Simple Sequence Repeats)領域を利用した品種識別マニュアルの作成に取り組んでいます。識別マニュアルは農林水産省のホームページに公開されています。
主な遺伝子の解析法として以下の様な方法があります。
【RAPD(Random Amplified Polymorphic DNA)法】
操作が簡単で迅速な検査ができることから、品種識別に使用されています。しかし、再現性についての問題が指摘されています。
【SSR(Simple Sequence Repeats)】
2~6塩基を単位とした縦列反復配列であり、ゲノム中に多数散在しています。その反復単位のくり返し数が品種により異なるため、SSRを含むDNA断片のサイズを比較することで品種の識別を可能とします。
【ITS(Internal Transcribed Spacer)】
ITS領域は、リボゾームRNAの遺伝子領域に存在し、そのITS領域の配列や長さは種によって特異的です。そのため、ITS領域のDNA配列を解析することで種の同一性を確認できます。

